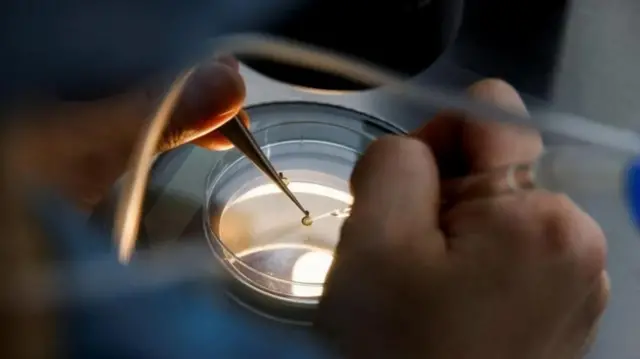
వైద్యం

మూడు దశాబ్దాల కిందటి పిండం, ఇప్పుడు మగబిడ్డ జన్మకు కారణమైంది, వైద్య ప్రపంచంలో మరో అద్భుతం

ఫొటో సోర్స్, Getty Images
- రచయిత, దానయ్ నెస్టా కుపెంబా
- హోదా, బీబీసీ ప్రతినిధి
- చదివే సమయం: 3 నిమిషాలు
అమెరికాలో ఓహియో రాష్ట్రానికి చెందిన దంపతులకు పుట్టిన బిడ్డ సరికొత్త రికార్డును సృష్టించినట్లు చెబుతున్నారు.
30 సంవత్సరాలకు పైగా దాచి ఉంచిన పిండం ద్వారా అమెరికన్ దంపతులకు మగ శిశువు జన్మించాడు.
35 ఏళ్ల లిండ్సే పియర్స్ అనే మహిళ, 34 ఏళ్ల టిమ్ పియర్స్ అనే పురుషుడు ఈ బిడ్డకు తల్లిదండ్రులు. జులై 26న పుట్టిన ఈ బిడ్డ ఆరోగ్యంగా ఉన్నాడు.
''మా కుటుంబానికి ఇదంతా సైన్స్ ఫిక్షన్ సినిమాలో జరిగే అద్భుతంలా ఉంది'' అని బిడ్డ తండ్రి టిమ్ పియర్స్ ఎంఐటీ టెక్నాలజీ రివ్యూతో మాట్లాడుతూ అన్నారు.
ఒక పిండాన్ని సృష్టించడానికి ఫ్రీజ్ చేసి ఉంచిన ఎంబ్రియోను ఉపయోగించి బిడ్డకు జన్మనిచ్చే టెక్నాలజీ ప్రస్తుతం అందుబాటులో ఉంది.
అయితే, అత్యంత ఎక్కువకాలం ఇలా ఫ్రీజ్ చేసిన ఎంబ్రియో ద్వారా పుట్టిన బిడ్డ మాత్రం ఇదేనని భావిస్తున్నారు.
గతంలో, 1992 నుంచి దాచి ఉంచిన పిండం ద్వారా 2022లో ఒక బిడ్డ జన్మించింది. ఇప్పటి వరకు ఉన్న రికార్డు ఇదే.

ఇన్నేళ్లు ఎందుకు ఉంచారు?
పియర్స్ దంపతులు ఏడు సంవత్సరాలుగా పిల్లల కోసం ప్రయత్నిస్తున్నారు. తర్వాత వారు లిండా ఆర్చర్ అనే మహిళ దాచి ఉంచిన పిండాన్ని దత్తత తీసుకున్నారు.
1994లో లిండా ఆర్చర్డ్ తన భర్తతో కలిసి సృష్టించిన పిండం ఈ దంపతులకు లభించింది. ప్రస్తుతం లిండా ఆర్చర్డ్ వయసు 62 ఏళ్లు. ఐవీఎఫ్ ద్వారా బిడ్డను కనాలనే ప్రయత్నంలో అప్పట్లో ఆమె తన భర్తతో కలిసి నాలుగు పిండాలను సృష్టించారు.
వాటిలో ఒకదానితో ఆమె ఆడబిడ్డకు జన్మనిచ్చారు. ఆమె బిడ్డకు ఇప్పుడు 30 సంవత్సరాలు. మిగతా మూడు పిండాలు నిల్వ చేసి ఉన్నాయి.
తర్వాత కొంతకాలానికి లిండా ఆర్చర్డ్, ఆమె భర్త విడాకులు తీసుకున్నారు. కానీ, ఆ పిండాలను ధ్వంసం చేయాలనిగానీ, పరిశోధన కోసం ఇవ్వాలనిగానీ, ఎవరో తెలియని దంపతులకు దానం చేయాలనిగానీ లిండా అనుకోలేదు.
ఫొటో సోర్స్, Reuters
బిడ్డ దేశం దాాటి వెళ్లకూడదని..
ఆ పిండం శిశువుగా మారినా, అది తనకు, తన కూతురుకు ఏదో ఒక విధంగా దగ్గరగా ఉండాలని లిండా కోరుకున్నారు.
క్రైస్తవ మతానికి సంబంధించిన పిల్లల దత్తత ఏజెన్సీ నైట్లైట్ క్రిస్టియన్ అడాప్షన్స్ అనే సంస్థతో పరిచయం ఏర్పడే వరకు, లిండా ఆర్చర్డ్ తన పిండాలను నిల్వ చేయడానికి ఏటా వేల డాలర్లు చెల్లిస్తూ వచ్చారు.
ఈ సంస్థ నియమాల ప్రకారం, దాతలు పిండాలను దత్తత తీసుకునే దంపతుల మతాన్ని, జాతీయతను తెలుసుకుని వారికి ఇవ్వొచ్చు.
లిండా ఆర్చర్డ్ తన పిండాన్ని వివాహితులైన కాకేసియన్ క్రైస్తవ జంటకు దత్తత ఇవ్వాలని కోరుకున్నారు.
''నా బిడ్డ దేశం విడిచి వెళ్లడం నాకు ఇష్టం లేదు. ఆ జంట అమెరికాలోనే ఉండాలని కోరుకున్నా'' అని ఆమె ఎంఐటీ టెక్నాలజీ రివ్యూతో చెప్పారు.
లిండా ఆర్చర్డ్ కోరిక మేరకు లిండ్సే పియర్స్, టిమ్ పియర్స్ దంపతులు పిండాన్ని దత్తత తీసుకునేందుకు ముందుకు వచ్చారు.
ఎంబ్రియో వయసుతో నిమిత్తం లేకుండా, బిడ్డను కనడానికి ఎంతకాలం ఫ్రీజ్ చేసి ఉంచిన దాన్నైనా తీసుకుని విజయవంతంగా గర్భం దాల్చేలా చేయడమే తమ లక్ష్యంగా భావించినట్లు వీరికి సంతాన సాఫల్య చికిత్సను అందించిన టెన్నెస్సీ రాష్ట్రంలోని రిజోయిజ్ ఫెర్టిలిటీ ఐవీఎఫ్ క్లినిక్ వెల్లడించింది.
తాను, తన భర్త ఏ రికార్డులను బద్దలు కొట్టాలని కోరుకోలేదని, కేవలం బిడ్డను కనాలని మాత్రం కోరుకున్నామని లిండ్సే పియర్స్ అన్నారు.
''నేనింకా బిడ్డను స్వయంగా చూడలేదు. నా బిడ్డలా ఉందని మాత్రం అనిపిస్తోంది'' అని ఎంఐటీ టెక్నాలజీ రివ్యూతో అన్నారు లిండా ఆర్చర్డ్.
(బీబీసీ కోసం కలెక్టివ్ న్యూస్రూమ్ ప్రచురణ)
(బీబీసీ తెలుగును వాట్సాప్,ఫేస్బుక్, ఇన్స్టాగ్రామ్, ట్విటర్లో ఫాలో అవ్వండి. యూట్యూబ్లో సబ్స్క్రైబ్ చేయండి.)

































